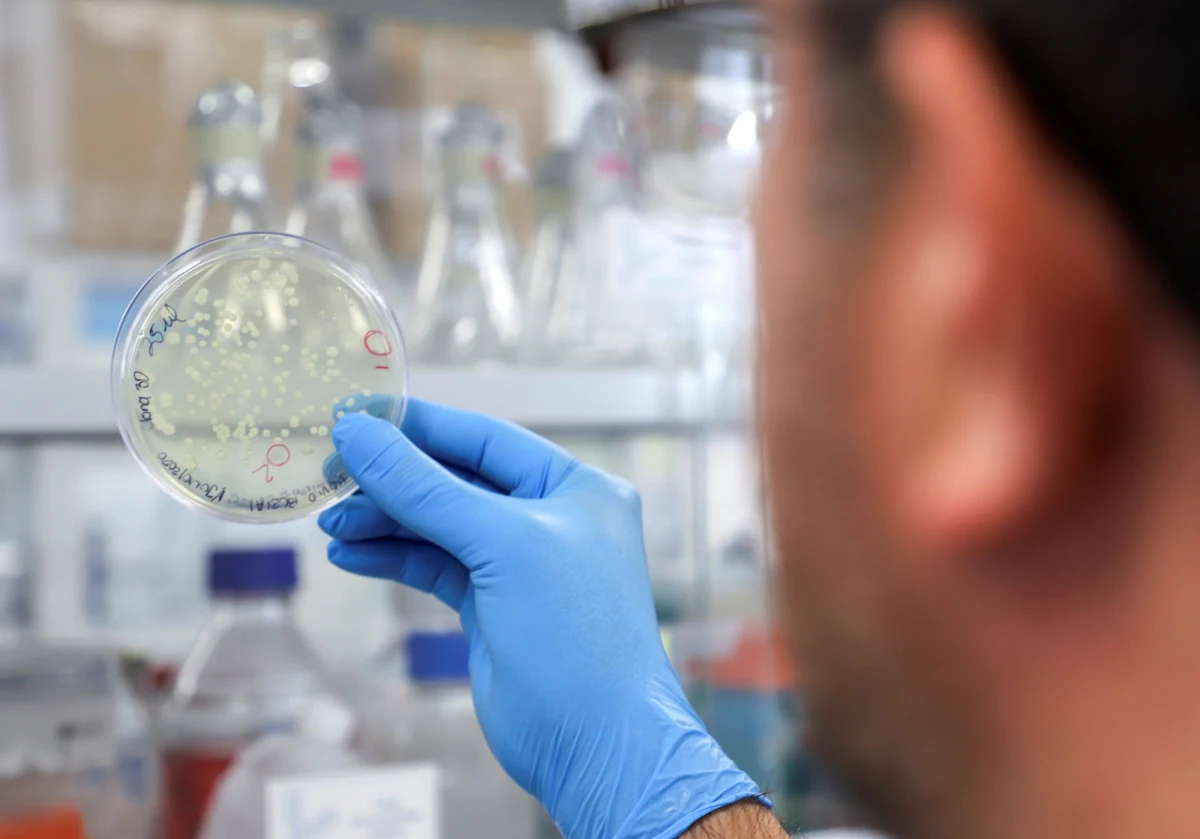
„Obecnie w różnych krajach świata stosuje się cztery chińskie szczepionki, ale wciąż posiadamy bardzo ograniczone informacje na ich temat” – przyznaje dr hab. Piotr Rzymski z Uniwersytetu Medycznego w Poznaniu.

„Obecnie w różnych krajach świata stosuje się cztery chińskie szczepionki, ale wciąż posiadamy bardzo ograniczone informacje na ich temat” – przyznaje dr hab. Piotr Rzymski z Uniwersytetu Medycznego w Poznaniu.
Mówiąc o "chińskiej szczepionce", tak naprawdę musimy używać liczby mnogiej. Obecnie cztery szczepionki chińskiego pochodzenia są na etapie bardziej zaawansowanych faz badań, ale zarazem dopuszczone do użytku w niektórych krajach - mówił ekspert w dziedzinie biologii medycznej i badań naukowych Uniwersytetu Medycznego im. Karola Marcinkowskiego w Poznaniu dr hab. Piotr Rzymski.
Dodał, że "preparaty chińskie mogą być dobrym narzędziem do walki z pandemią, ale to wymaga przedstawienia konkretnych, szczegółowych danych dotyczących badań klinicznych, w tym badań klinicznych trzeciej fazy - a ich póki co brak" - powiedział.
Rzymski tłumaczył, że wśród tych czterech chińskich preparatów jest jedna szczepionka wektorowa, zaś trzy są szczepionkami inaktywowanymi, czyli opartymi o całego, ale unieszkodliwionego koronawirusa - nie jest on w stanie namnażać się w komórkach człowieka, rozprzestrzeniać w organizmie i powodować Covid-19.
Na ten moment, mimo że wszystkie cztery chińskie szczepionki zostały dopuszczone do użycia w różnych krajach - oczywiście nie na terenie UE - to wciąż upubliczniono ograniczone informacje na ich temat. Na chwilę obecną, trudno jest stwierdzić, czy są to szczepionki skuteczne i do jakiego stopnia. To wymaga wpierw szczegółowych danych, również z badań trzeciej fazy oraz pełnej dokumentacji przedstawionej instytucji regulatorowej na terenie UE, czyli Europejskiej Agencji Leków (EMA). Tego typu dane nie zostały przedłożone, żaden z producentów chińskich szczepionek nie złożył wniosku o autoryzację swojego preparatu do EMA - zaznaczył.
Szczepionki oparte o inaktywowanego koronawirusa produkowane są przez Sinovac oraz Sinofarm, który wyprodukował dwa preparaty przeciw Covid-19.
Szczepionka Sinovac jest podawana w dwóch, oddzielonych o 2 tygodnie, dawkach. Wszystko co o niej wiemy, opiera się tylko o wyniki badania łączonej pierwszej i drugiej fazy klinicznej, łącznie obejmującej 743 uczestników do 59. roku życia. Nie są to badania bardzo szerokie, a jedynie wstępne. Prowadzono je natomiast w tzw. złotym standardzie - były to badania randomizowane, kontrolowane przez placebo, podwójnie zaślepione. Ale potrzebne są dane z fazy trzeciej, która jest swoistym testem bojowym dla preparatów leczniczych. W przypadku szczepionek pozwala zebrać liczne dane dotyczące ich bezpieczeństwa i skuteczności - mówił.
W przypadku Sinovac trzecia faza została uruchomiona w Brazylii, Turcji i Indonezji. Producent informował, że w badaniach brazylijskich skuteczność wynosiła ok. 50 proc., czyli była w zakresie minimalnego poziomu, który musi być spełniony przez szczepionki przeciw Covid-19. Z kolei dla badania tureckiego, raportowana skuteczność miała osiągać poziom ponad 80 proc. Są to jednak dane póki co niepublikowane, mają charakter tylko i wyłącznie informacji prasowych i w związku z tym nie sposób ich zweryfikować - dodał.
Preparaty firmy Sinofarm to dwie szczepionki inaktywowane, czyli wykorzystujące podobnie jak Sinovac całego koronawirusa, który jest martwy.
W przypadku szczepionek Sinofarm również mamy wyniki tylko z łączonych pierwszej i drugiej fazy. Badania te były randomizowane, kontrolowane przez placebo i podwójnie zaślepione. Według danych niepublikowanych - jedna i druga szczepionka ma mieć ponad 70 proc. skuteczności. Ale znowu nie sposób tego ocenić bez konkretnej dokumentacji, bez szczegółowych wyników, bo to są informacje tylko i wyłącznie prasowe. Szczepionki Sinofarmu też są już dopuszczone w różnych krajach - mówił.
Rzymski wskazał, że dla jednej ze szczepionek Sinofarm są dane eksperymentalne - opublikowane w formie tzw. preprintu, czyli surowego manuskryptu, który nie został jeszcze opublikowany na łamach czasopisma naukowego - które wskazują, że przeciwciała u osób zaszczepionych zachowują zdolność neutralizacji wariantu południowoafrykańskiego. Jedna ze szczepionek Sinofarm jest dwudawkowa i podawana jest w odstępie 3 tygodni, zaś druga szczepionka w badaniach klinicznych była podawana w trzech dawkach; druga po 4 tygodniach, a trzecia dawka po kolejnych 4.
Mamy też szczepionkę wektorową produkowaną przez CanSino. To jest szczepionka jednodawkowa, podobnie jak szczepionka Johnson & Johnson, z tą różnicą, że wektor J&J wykorzystuje ludzkiego adenowirusa typu 26., a CanSino ludzkiego adenowirusa typu 5. Pierwsza faza badań tej szczepionki obejmowała 108 uczestników, druga faza 508 uczestników. Badania trzeciej fazy są prowadzone obecnie w Pakistanie, Rosji, Meksyku, i w Chile. Według informacji podanej przez producenta mediom, skuteczność ma wynosić 65 proc. - ale szczegóły nie są znane, dane nie są opublikowane - zaznaczył.
Szczepionka ta dopuszczona jest już do użycia w Chinach, Pakistanie i Meksyku.